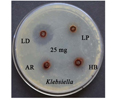
Cover Image

Table of Contents
Research Articles
|
Rijuraj M.P., Rajendraprasad M., Shareef S.M., Shaju T.
|
3749-3754
|
|
An account of the Gymnospermic flora of Himachal Pradesh and different uses in daily life of peoples
Priya Kumari, Mukesh Kumar Seth, Rakhi Gagotia
|
3755-3760
|
|
Ravi Prasad Rao Boyina, Sreenath Ananthaneni
|
3761-3766
|
|
Bihari Singh, Rajesh Kumar, Arvind Kumar Nag, Anil Kumar Singh, Prashant Chandra, Vishal Patel
|
3767-3773
|
|
Ramesh Kumar, Abdin M.Z., Vidyanath Jha, Singh I.S., Amit Kumar
|
3774-3777
|
|
Padmavathi Naga V., Sailaja V. J., Madhava Chetty K.
|
3778-3782
|